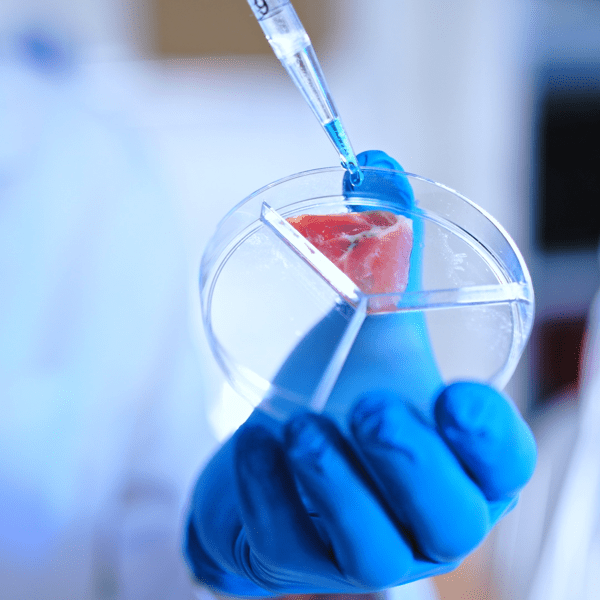
CW_Web_Asset_Food Lab
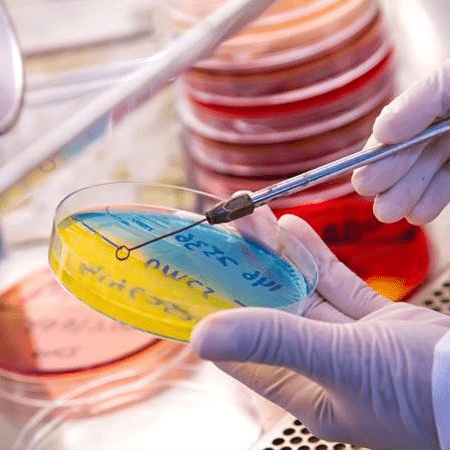
CW_Web_Asset_Lab 2

About
Laboratory products and
waste disposal services

Comprehensive waste management for laboratories, including disposal of chemical, biological and sharps waste, plus supply of purpose-fit containers.
Running a laboratory often involves handling waste streams that may fall under strict regulatory requirements in Australia, while also maintaining specimen quality and supporting a safe work environment. Cleanaway’s specialised services and product range are designed to help you meet these needs.
We offer a comprehensive laboratory waste disposal service that strives to safely handle biohazardous materials, chemicals and contaminated items. Through safe collection, through to transport and treatment. Delivered through our specialist healthcare and hazardous waste divisions – including Cleanaway Daniels – our services are structured to support labs across Australia in working towards their safety, compliance and sustainability goals.
Whether you operate in pathology, research, education, pharmaceuticals or diagnostics, you can count on Cleanaway to expertly handle all laboratory waste streams, including solvents, reagents, sharps, biohazards and clinical trial waste.
Clinical and hazardous laboratory waste
Contaminated tissues, samples, sharps, medicines, expired chemicals, cytotoxic materials, and infectious lab waste.
Chemical and equipment disposal
Hazardous and non-hazardous chemicals, broken glassware, contaminated containers and lab instruments for safe decontamination or disposal.
Service
Who our laboratory waste solutions support

Healthcare and pathology
Hospitals, pathology labs, diagnostic centres, and clinical research facilities.

Pharmaceutical and biotech
Drug manufacturers, biotech companies, and R&D laboratories.

Education and research
Universities, TAFEs, and private or government research institutions.
Industrial and environmental testing
Food and beverage testing, environmental monitoring labs, and product quality control facilities.
![]()
Process
Laboratory waste management process
Our comprehensive waste management process aims to help you mitigate the health, safety and environmental risks that can be associated with collecting and disposing of laboratory waste.
Comprehensive
Product lines for research and clinical laboratories
Bags
Our medical and lab waste disposal bags are engineered for ease of use, space efficiency and performance, purpose-designed for specific waste streams, and include high-strength construction and autoclavable options. We strive to customise bags to suit a range of applications and volumes.
Infection control barrier for x-ray DR detectors
Detector sleeves help prevent contamination from blood and body fluids, helping to reduce infection risks for patients and staff.
Specimen collection containers
Our laboratory and pathology specimen containers are designed with regulatory requirements in mind and aim to minimise exposure risk. Their plastic construction is leak-resistant and made from materials that help reduce leaching and cross-contamination. Clear labelling can be provided and tailored to specific applications.
Customisable spill response kits
Our ready-to-use spill kits are designed for fast response to hazardous or infectious liquid spills in clinical and laboratory settings. Custom kits can be designed to meet your specific workplace safety protocols.
Laboratory consumables
We offer a wide selection of products to support clinical, pathology and research labs.
BIO-CAN containers
BIO-CAN offers cost effective, safe containment of sharps, cytotoxic and clinical waste. Made in Australia with a low-pollutant plastic that reduces the risk of needle penetration, our BIO-CAN range can help you in working towards optimal standards of safety and environmental sustainability.
Specimen transport bags and tube mailers
Developed to align with relevant government guidelines, our specimen bags and tube mailers are leak-resistant and help protect biological materials and pathology samples from contamination during transport.
![]()
Output
What happens to laboratory waste
We treat clinical trial waste, research waste and other laboratory waste so that it can be securely disposed of. Treatment methods vary according to the type of waste and associated regulations – it may require high-temperature incineration, autoclave sterilisation or chemical neutralisation. Where possible, materials are recovered after treatment, for example, solvents.
Our promise
Why choose Cleanaway

A one-stop solution
We offer an expansive range of services, custom waste solutions and expert support to meet the waste management and resource recovery needs of Australian businesses, councils and industries of any size.

Making a sustainable future possible together
We’re leading the way in sustainable waste management and resource recovery, helping Australia to transition to a circular economy and investing in lasting solutions for the benefit of all Australians – now and into the future.

Health, safety and environmental focus
We implement rigorous controls to safely collect, treat and dispose of waste, minimising the risk of harm to people and the environment while meeting strict compliance standards.

Market-leading infrastructure
Our EPA-licensed, state-of-the-art facilities enable safe, efficient waste processing and resource recovery at scale.